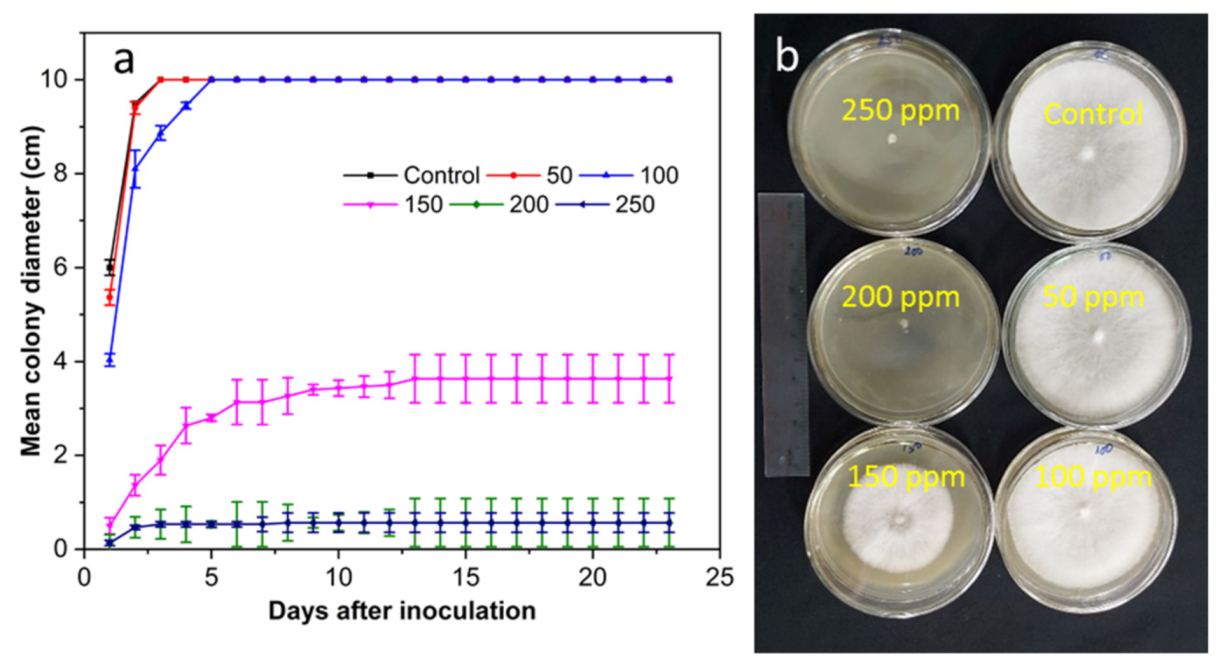
Coatings 12 00235 g005 550
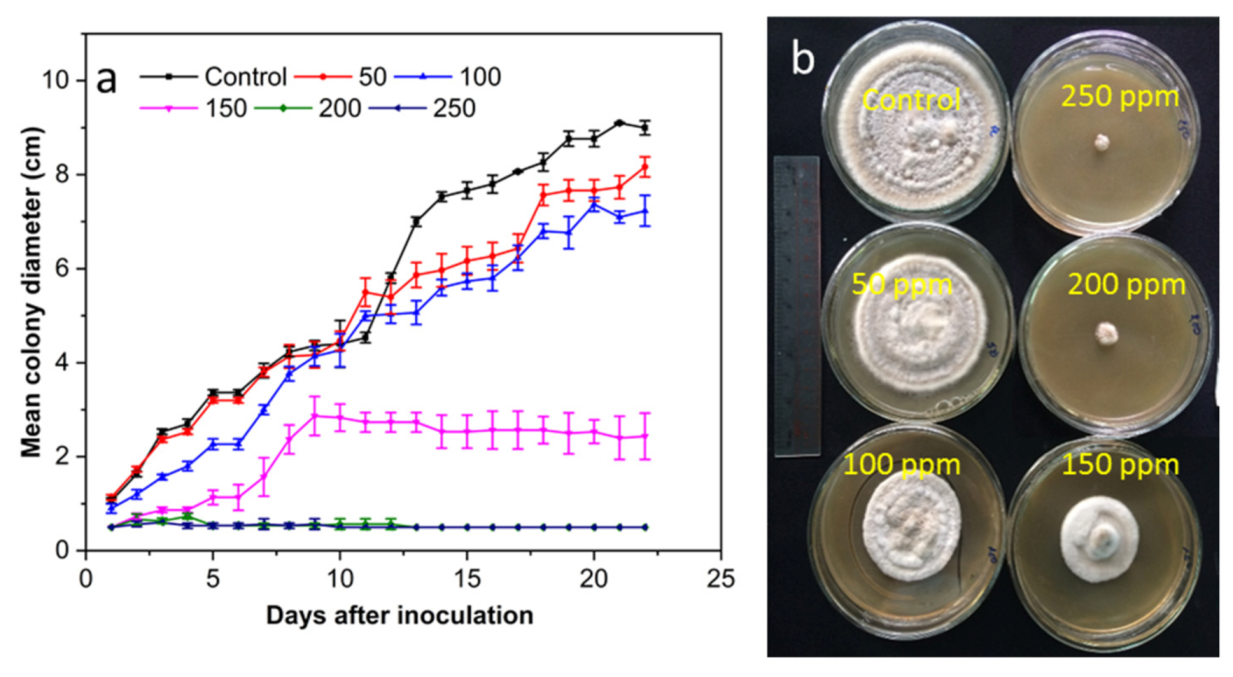
Coatings 12 00235 g006 550
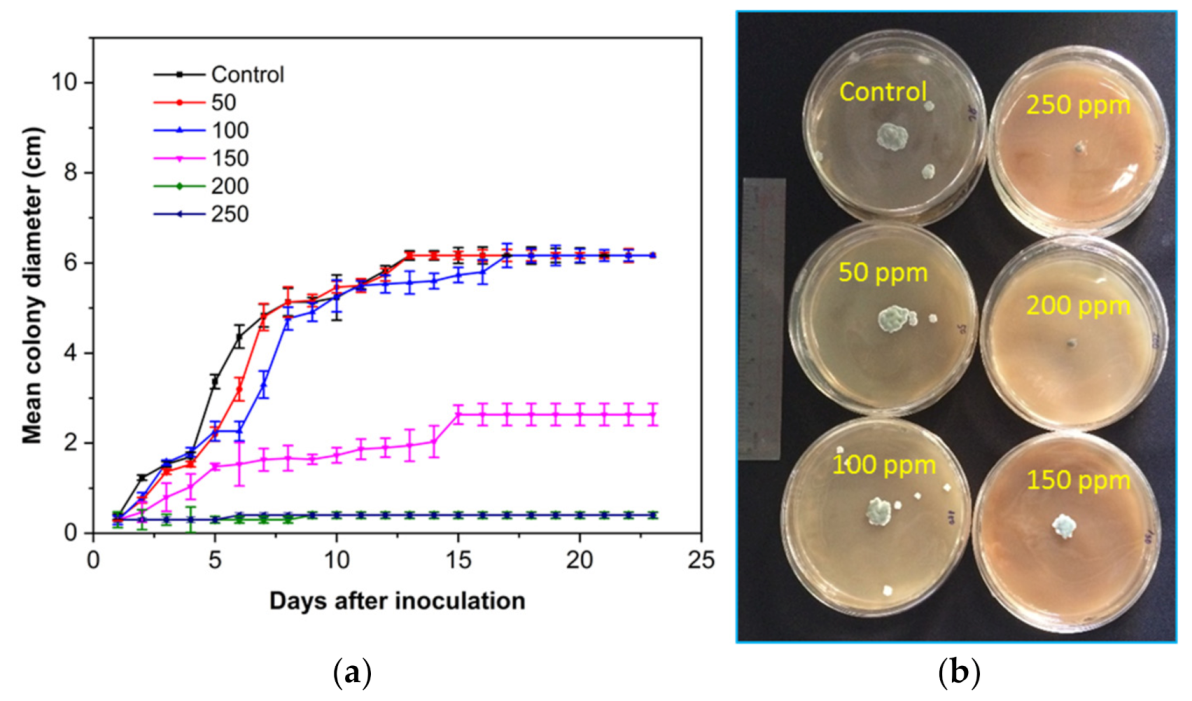
Coatings 12 00235 g007 550

Antifungal Activity of Squid Pen Chitosan Nanoparticles against Three Fungal Pathogens in Various Citrus Fruits In Vitro and In Vivo
Abstract
:1. Introduction
2. Materials and Methods
2.1. Preparation of SCNs
2.2. Fruits Samples
2.3. Pathogen Isolation and Identification
2.4. Antifungal Test
2.5. Statistical Analysis
3. Results and Discussion
3.1. Isolation and Identification of the Fungi from Citrus Fruits
3.2. Pathogenicity Test
4. Conclusions
Author Contributions
Funding
Institutional Review Board Statement
Informed Consent Statement
Data Availability Statement
Conflicts of Interest
References
- Tabti, L.; El Amine Dib, M.; Djabou, N.; Benyelles, N.G.; Paolini, J.; Costa, J.; Muselli, A. Control of fungal pathogens of Citrus sinensis L. by essential oil and hydrosol of Thymus capitatus L. J. Appl. Bot. Food Qual. 2014, 87, 279–285. [Google Scholar]
- Tripathi, P.; Dubey, N.K. Exploitation of natural products as an alternative strategy to control postharvest fungal rotting of fruit and vegetables. Postharvest Biol. Technol. 2004, 32, 235–245. [Google Scholar] [CrossRef]
- Porat, R.; Daus, A.; Weiss, B.; Cohen, L.; Fallik, E.; Droby, S. Reduction of postharvest decay in organic citrus fruit by a short hot water brushing treatment. Postharvest Biol. Technol. 2000, 18, 151–157. [Google Scholar] [CrossRef]
- Chen, J.; Zhu, Z.; Fu, Y.; Cheng, J.; Xie, J.; Lin, Y. Identification of Lasiodiplodia pseudotheobromae causing fruit rot of Citrus in China. Plants 2021, 10, 202. [Google Scholar] [CrossRef] [PubMed]
- Erasmus, A.; Lennox, C.L.; Korsten, L.; Lesar, K.; Fourie, P.H. Imazalil resistance in Penicillium digitatum and P. italicum causing citrus postharvest green and blue mould: Impact and options. Postharvest Biol. Technol. 2015, 107, 66–76. [Google Scholar] [CrossRef] [Green Version]
- Costa, J.H.; Bazioli, J.M.; de Moraes Pontes, J.G.; Fill, T.P. Penicillium digitatum infection mechanisms in citrus: What do we know so far? Fungal Biol. 2019, 123, 584–593. [Google Scholar] [CrossRef]
- Goosen, M.F. (Ed.) Applications of Chitan and Chitosan; CRC Press: Boca Raton, FL, USA, 1996. [Google Scholar]
- KaimBilla, R.E.; Islam, M.A.; Agunaou, M.; Soufiane, A. A promising chitosan/fluorapatite composite for efficient removal of lead (II) from an aqueous solution. Arab. J. Geosci. 2021, 14, 1134–1145. [Google Scholar] [CrossRef]
- Pichyangkura, R.; Chadchawan, S. Biostimulant activity of chitosan in horticulture. Sci. Hortic. 2015, 196, 49–65. [Google Scholar] [CrossRef]
- Baños, S.B.; López, M.H.; Molina, E.B. Growth inhibition of selected fungi by chitosan and plant extracts. Rev. Mex. Fitopatol. 2004, 22, 178–186. [Google Scholar]
- Mohamed, M.D.; Moharam, M.H.; Ahmed, H.A. In vitro and in vivo toxicity of nano chitosan against Curvularia lunata, the causal microorganism of fruit rot and blight, a new disease of olive (O. europaea L.). Eur. J. Plant Pathol. 2021, 161, 881–894. [Google Scholar] [CrossRef]
- Pabón-Baquero, D.; Velázquez-del Valle, M.G.; Evangelista-Lozano, S.; León-Rodriguez, R.; Hernández-Lauzardo, A.N. Chitosan effects on phytopathogenic fungi and seed germination of Jatropha curcas L. Rev. Chapingo Ser. Cienc. For. Ambiente 2015, 21, 241–253. [Google Scholar] [CrossRef]
- Rodríguez, A.T.; Ramírez, M.A.; Cárdenas, R.M.; Hernández, A.N.; Velázquez, M.G.; Bautista, S. Induction of defense response of Oryza sativa L. against Pyricularia grisea (Cooke) Sacc. by treating seeds with chitosan and hydrolyzed chitosan. Pestic. Biochem. Phys. 2007, 89, 206–215. [Google Scholar] [CrossRef]
- Yang, J.; Tian, F.; Wang, Z.; Wang, Q.; Zeng, Y.J.; Chen, S.Q. Effect of chitosan molecular weight and deacetylation degree on hemostasis. J. Biomed. Mater. Res. 2008, 84, 131–137. [Google Scholar] [CrossRef]
- Sathiyabama, M.; Parthasarathy, R. Biological preparation of chitosan nanoparticles and its in vitro antifungal efficacy against some phytopathogenic fungi. Carbohydr. Polym. 2016, 151, 321–325. [Google Scholar] [CrossRef]
- Shukla, S.K.; Mishra, A.K.; Arotiba, O.A.; Mamba, B.B. Chitosan-based nanomaterials: A state-of-the-art review. Int. J. Biol. Macromol. 2013, 59, 46–58. [Google Scholar] [CrossRef]
- Mohammed, S.R.; Zeitar, E.M.; Eskov, I.D. Inhibition of mycelial growth of Rhizoctonia solani by chitosan in vitro and in vivo. Open Agric. J. 2019, 13, 156–161. [Google Scholar] [CrossRef]
- Cuevas-Acuña, D.A.; Plascencia-Jatomea, M.; Santacruz-Ortega, H.D.C.; Torres-Arreola, W.; Ezquerra-Brauer, J.M. Development of chitosan/squid skin gelatin hydrolysate films: Structural, physical, antioxidant, and antifungal properties. Coatings 2021, 11, 1088. [Google Scholar] [CrossRef]
- Azhar, I.S.; Narisya, L. Antifungal power of chitosan extract from squid pen powder towards Candida albicans. Eur. Asian J. Biosci. 2020, 14, 3769–3772. [Google Scholar]
- Xing, Y.; Wang, X.; Guo, X.; Yang, P.; Yu, J.; Shui, Y.; Chen, C.; Li, X.; Xu, Q.; Xu, L.; et al. Comparison of Antimicrobial Activity of Chitosan Nanoparticles against Bacteria and Fungi. Coatings 2021, 11, 769. [Google Scholar] [CrossRef]
- Yien, L.; Zin, N.M.; Sarwar, A.; Katas, H. Antifungal activity of chitosan nanoparticles and correlation with their physical properties. Int. J. Biomater. 2012, 2012, 632698. [Google Scholar]
- Orellano, M.S.; Isaac, P.; Breser, M.L.; Bohl, L.P.; Conesa, A.; Falcone, R.D.; Porporatto, C. Chitosan nanoparticles enhance the antibacterial activity of the native polymer against bovine mastitis pathogens. Carbohydr. Polym. 2019, 213, 1–9. [Google Scholar] [CrossRef]
- Kritchenkov, A.S.; Zhaliazniak, N.V.; Egorov, A.R.; Lobanov, N.N.; Volkova, O.V.; Zabodalova, L.A.; Suchkova, E.P.; Kurliuk, A.V.; Shakola, T.V.; Rubanik, V.V., Jr.; et al. Chitosan derivatives and their based nanoparticles: Ultrasonic approach to the synthesis, antimicrobial and transfection properties. Carbohydr. Polym. 2020, 242, 116478. [Google Scholar] [CrossRef] [PubMed]
- Abdallah, Y.; Liu, M.; Ogunyemi, S.O.; Ahmed, T.; Fouad, H.; Abdelazez, A.; Yan, C.; Yang, Y.; Chen, J.; Li, B. Bioinspired green synthesis of chitosan and zinc oxide nanoparticles with strong antibacterial activity against rice pathogen Xanthomonas oryzae pv. oryzae. Molecules 2020, 25, 4795. [Google Scholar] [CrossRef]
- Bautista-Baños, S.; Hernandez-Lauzardo, A.N.; Velazquez-Del Valle, M.G.; Hernández-López, M.; Barka, E.A.; Bosquez-Molina, E.; Wilson, C.L. Chitosan as a potential natural compound to control pre and postharvest diseases of horticultural commodities. J. Crop Prot. 2006, 25, 108–118. [Google Scholar] [CrossRef]
- Xu, H.; Ma, L.; Shi, H.; Gao, C.; Han, C. Chitosan–hyaluronic acid hybrid film as a novel wound dressing: In vitro and in vivo studies. Polym. Adv. Technol. 2007, 18, 869–875. [Google Scholar] [CrossRef]
- Hernandez-Lauzardo, A.N.; Velázquez-del Valle, M.G.; Guerra-Sanchez, M.G. Current status of action mode and effect of chitosan against phytopathogens fungi. Afr. J. Microbiol. Res. 2011, 5, 4243–4247. [Google Scholar] [CrossRef]
- Cuong, H.N.; Minh, N.C.; Hoa, N.V.; Trung, T.S. Preparation and characterization of high purity β-chitin from squid pens (Loligo chenisis). Int. J. Biol. Macromol. 2016, 93, 442–447. [Google Scholar] [CrossRef]
- Hoa, N.V.; Vuong, N.T.H.; Minh, N.C.; Cuong, H.N.; Trung, T.S. Squid pen chitosan nanoparticles: Small size and high antibacterial activity. Polym. Bull. 2021, 78, 7313–7324. [Google Scholar]
- Benbouazza, A.; Douira, A. First report of olive anthracnose, caused by Colletotrichum gloeosporioides, in Morocco. Atlas J. Biol. 2013, 2, 171–174. [Google Scholar]
- Gomes, A.C.A.; da Costa Lima, M.; de Oliveira, K.Á.R.; dos Santos Lima, M.; Magnani, M.; Câmara, M.P.S.; de Souza, E.L. Coatings with chitosan and phenolic-rich extract from acerola (Malpighia emarginata DC) or jabuticaba (Plinia jaboticaba (Vell.) Berg) processing by-product to control rot caused by Lasiodiplodia spp. in papaya (Carica papaya L.) fruit. Int. J. Food Microb. 2020, 331, 108694. [Google Scholar] [CrossRef]
- Meng, X.; Yang, L.; Kennedy, J.F.; Tian, S. Effects of chitosan and oligochitosan on growth of two fungal pathogens and physiological properties in pear fruit. Carbohydr. Polym. 2010, 81, 70–75. [Google Scholar] [CrossRef]
- Waewthongrak, W.; Pisuchpen, S.; Leelasuphakul, W. Effect of Bacillus subtilis and chitosan applications on green mold (Penicilium digitatum Sacc.) decay in citrus fruit. Postharvest Biol. Technol. 2015, 99, 44–49. [Google Scholar] [CrossRef]
- El Ghaouth, A.; Ponnampalam, R.; Castaigne, F.; Arul, J. Chitosan coating to extend the storage life of tomatoes. Hortic. Sci. 1992, 27, 1016–1018. [Google Scholar] [CrossRef] [Green Version]
- Jiang, Y.; Li, Y. Effects of chitosan coating on postharvest life and quality of longan fruit. Food Chem. 2001, 73, 139–143. [Google Scholar] [CrossRef]
- Liu, J.; Tian, S.; Meng, X.; Xu, Y. Effects of chitosan on control of postharvest diseases and physiological responses of tomato fruit. Postharvest Biol. Technol. 2007, 44, 300–306. [Google Scholar] [CrossRef]
- Saharan, V.; Mehrotra, A.; Khatik, R.; Rawal, P.; Sharma, S.S.; Pal, A. Synthesis of chitosan based nanoparticles and their in vitro evaluation against phytopathogenic fungi. Int. J. Biol. Macromol. 2013, 62, 677–683. [Google Scholar] [CrossRef]

| SCNs (ppm) | Infection (%) | Mean Lesion Diameter (cm) | ||
|---|---|---|---|---|
| P. digitatum | L. pseudotheobromae | A. alternate | ||
| 0 | 100 | 15.0 | 15.0 | 15.0 |
| 50 | 100 | 15.0 | 15.0 | 15.0 |
| 100 | 85.3 | 9.3 | 10.1 | 12.3 |
| 150 | 51.9 | 5.9 | 5.5 | 6.6 |
| 200 | 15.6 | 2.1 | 1.7 | 2.3 |
| 250 | 0.0 | 0.0 | 0.0 | 0.0 |
| SCNs (ppm) | Infection (%) | Mean Lesion Diameter (cm) | ||
|---|---|---|---|---|
| P. digitatum | L. pseudotheobromae | A. alternate | ||
| 0 | 100 | 9.5 | 9.5 | 9.5 |
| 50 | 100 | 9.5 | 9.5 | 9.5 |
| 100 | 95.3 | 8.3 | 9.3 | 9.1 |
| 150 | 61.9 | 4.9 | 5.5 | 4.6 |
| 200 | 25.6 | 3.1 | 4.7 | 2.3 |
| 250 | 0.7 | 0.5 | 1.0 | 0.6 |
| SCNs (ppm) | Infection (%) | Mean Lesion Diameter (cm) | ||
|---|---|---|---|---|
| P. digitatum | L. pseudotheobromae | A. alternate | ||
| 0 | 100 | 6.5 | 6.5 | 6.5 |
| 50 | 100 | 6.5 | 6.5 | 6.3 |
| 100 | 85.3 | 5.3 | 5.1 | 4.3 |
| 150 | 51.9 | 3.9 | 3.5 | 3.6 |
| 200 | 15.5 | 1.1 | 2.7 | 1.2 |
| 250 | 0.3 | 0.0 | 0.0 | 0.6 |
Publisher’s Note: MDPI stays neutral with regard to jurisdictional claims in published maps and institutional affiliations. |
© 2022 by the authors. Licensee MDPI, Basel, Switzerland. This article is an open access article distributed under the terms and conditions of the Creative Commons Attribution (CC BY) license (https://creativecommons.org/licenses/by/4.0/).
Share and Cite
Cuong, H.N.; Minh, N.C.; Hoa, N.V.; Giang, D.H.; Hieu, N.V.; Nam, P.V. Antifungal Activity of Squid Pen Chitosan Nanoparticles against Three Fungal Pathogens in Various Citrus Fruits In Vitro and In Vivo. Coatings 2022, 12, 235. https://doi.org/10.3390/coatings12020235
Cuong HN, Minh NC, Hoa NV, Giang DH, Hieu NV, Nam PV. Antifungal Activity of Squid Pen Chitosan Nanoparticles against Three Fungal Pathogens in Various Citrus Fruits In Vitro and In Vivo. Coatings. 2022; 12(2):235. https://doi.org/10.3390/coatings12020235
Chicago/Turabian StyleCuong, Hoang Ngoc, Nguyen Cong Minh, Nguyen Van Hoa, Dang Ha Giang, Nguyen Van Hieu, and Pham Viet Nam. 2022. "Antifungal Activity of Squid Pen Chitosan Nanoparticles against Three Fungal Pathogens in Various Citrus Fruits In Vitro and In Vivo" Coatings 12, no. 2: 235. https://doi.org/10.3390/coatings12020235
APA StyleCuong, H. N., Minh, N. C., Hoa, N. V., Giang, D. H., Hieu, N. V., & Nam, P. V. (2022). Antifungal Activity of Squid Pen Chitosan Nanoparticles against Three Fungal Pathogens in Various Citrus Fruits In Vitro and In Vivo. Coatings, 12(2), 235. https://doi.org/10.3390/coatings12020235

